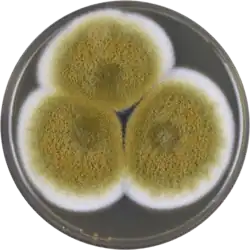

Aspergillus tamarii
| Aspergillus tamarii | ||||||||||||
|---|---|---|---|---|---|---|---|---|---|---|---|---|
Aspergillus tamarii auf CYA-Agar | ||||||||||||
| Systematik | ||||||||||||
| ||||||||||||
| Wissenschaftlicher Name | ||||||||||||
| Aspergillus tamarii | ||||||||||||
Aspergillus tamarii ist ein Schimmelpilz aus der Gattung der Gießkannenschimmel (Aspergillus sp.), der als eine Form des gelben Kōji zur Fermentation von Tamari-Sojasauce verwendet wird.[1][2][3] A. tamarii wurde erstmals 1913 von G. Kita beschrieben.[4]
Aufbau & Vorkommen
A. tamarii besitzt einen Fruchtkörper und septierte Hyphen, wodurch er ein echtes Myzel bilden kann. Sein Wachstum in Myzel-Form beginnt exponentiell, verlangsamt sich jedoch anschließend. Er gedeiht besonders gut in organischen Böden, Stroh oder Kompost. Neben dem Wachstum als Myzel vermehrt er sich auch durch Konidien.[5] A. tamarii ist hauptsächlich in tropischen und subtropischen Regionen zu finden und gelangt hauptsächlich durch den Import von Nüssen in mitteleuropäische Gebiete.[5][6] In sehr seltenen Fällen kann A. tamarii eine Aspergillose auslösen.[7] A. tamarii produziert das Toxin Cyclopiazonsäure[8][9][10] und das Fungizid Aspirochlorin.[11]
Einzelnachweise
- ↑ K. Ito, A. Matsuyama: Koji Molds for Japanese Soy Sauce Brewing: Characteristics and Key Enzymes. In: Journal of fungi. Band 7, Nummer 8, August 2021, S. , doi:10.3390/jof7080658, PMID 34436196, PMC 8399179 (freier Volltext). (englisch)
- ↑ C. Diez-Simon, C. Eichelsheim, R. Mumm, R. D. Hall: Chemical and Sensory Characteristics of Soy Sauce: A Review. In: Journal of agricultural and food chemistry. Band 68, Nummer 42, Oktober 2020, S. 11612–11630, doi:10.1021/acs.jafc.0c04274, PMID 32880168, PMC 7581291 (freier Volltext). (englisch)
- ↑ S. C. Jong, J. M. Birmingham: Current status of fungal culture collections and their role in biotechnology. In: Handbook of applied mycology, 1992, Band 4: Fungal biotechnology (Arora DK, Elander RP, Murekji KG, eds) New York: Marcel Dekker. ISBN 978-0-4292-1652-7. S. 993–1024.
- ↑ G. Kita: Einige japanische Schimmelpilze. In: Centralbl. Bakteriol., 1913, Abt. 2, Band 37, S. 433–452.
- ↑ a b Naiba Nabieva, No, Benedikt Hofer: Aspergillus tamarii. Synonyme: Schimmelpilz, Gießkannenschimmel. In: DocCheck Flexikon. Abgerufen am 26. Januar 2025.
- ↑ A.D. Hocking: Aspergillus and related teleomorphs. In: Food Spoilage Microorganisms. ScienceDirect, 2006, abgerufen am 14. Mai 2024 (englisch).
- ↑ Felix Bongomin, C. R. Batac, Malcolm Richardson, David W. Denning: A Review of Onychomycosis Due to Aspergillus Species. In: Mycopathologia. 2017, Band 183, Nummer 3, S. 485–493 doi:10.1007/s11046-017-0222-9. PMID 29147866. PMC 5958150 (freier Volltext).
- ↑ J. W. Dorner: Production of cyclopiazonic acid by Aspergillus tamarii Kita. In: Applied and Environmental Microbiology. Band 46, Nummer 6, Dezember 1983, S. 1435–1437, doi:10.1128/aem.46.6.1435-1437.1983, PMID 6660879, PMC 239590 (freier Volltext).
- ↑ J. C. Frisvad, V. Hubka, C. N. Ezekiel, S. B. Hong, A. Nováková, A. J. Chen, M. Arzanlou, T. O. Larsen, F. Sklenář, W. Mahakarnchanakul, R. A. Samson, J. Houbraken: Taxonomy of section and their production of aflatoxins, ochratoxins and other mycotoxins. In: Studies in mycology. Band 93, Juni 2019, S. 1–63, doi:10.1016/j.simyco.2018.06.001, PMID 30108412, PMC 6080641 (freier Volltext).
- ↑ M. Homa, P. Manikandan, A. Szekeres, N. Kiss, S. Kocsubé, L. Kredics, B. Alshehri, A. A. Dukhyil, R. Revathi, V. Narendran, C. Vágvölgyi, C. S. Shobana, T. Papp: Characterization of Strains From Human Keratomycoses: Molecular Identification, Antifungal Susceptibility Patterns and Cyclopiazonic Acid Producing Abilities. In: Frontiers in Microbiology. Band 10, 2019, S. 2249, doi:10.3389/fmicb.2019.02249, PMID 31649626, PMC 6794953 (freier Volltext).
- ↑ J. Varga, J. C. Frisvad, R. A. Samson: Two new aflatoxin producing species, and an overview of Aspergillus section Flavi. In: Studies in mycology. Band 69, Nummer 1, Juni 2011, S. 57–80, doi:10.3114/sim.2011.69.05, PMID 21892243, PMC 3161756 (freier Volltext).